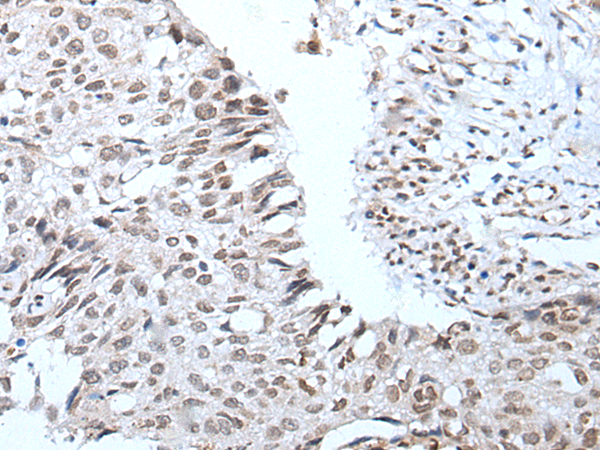

-
分类: 科研抗体货号: P06001别名: SPAG4L; SPGF16; TSARG4; dJ726C3.1应用: WB,IHC反应种属: Human, Mouse
-
分类: 科研抗体货号: P06053别名: CAP23; NAP22; CAP-23; NAP-22应用: IHC反应种属: Human
-
分类: 科研抗体货号: P06000别名: WICH; WIRE应用: WB,IHC反应种属: Human
-
分类: 科研抗体货号: P06051别名: CT2.2应用: WB,IHC反应种属: Human
-
分类: 科研抗体货号: P06043别名: SCA7; OPCA3; ADCAII应用: IHC反应种属: Human, Mouse
-
分类: 科研抗体货号: P06090别名: CPN2; ALDOS; CYP11B; CYP11BL; CYPXIB2; P450C18; P-450C18; P450aldo应用: WB,IHC反应种属: Human
-
分类: 科研抗体货号: P06037别名: NPA1; C21orf108应用: IHC反应种属: Human
-
分类: 科研抗体货号: P06089别名: MEI5; MEIR5; C10orf78; bA373N18.1应用: IHC反应种属: Human, Mouse, Rat
-
分类: 科研抗体货号: P06034别名: IIAE1; UNC93; UNC93B; Unc-93B1应用: IHC反应种属: Human, Mouse
-
分类: 科研抗体货号: P06088别名: D123; C10orf7应用: WB反应种属: Human, Mouse, Rat

鄂公网安备42018502007531号
鄂公网安备42018502007531号

